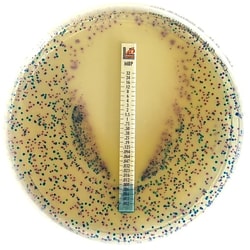
Liofilchem&trade;&nbsp;Chromatic MH
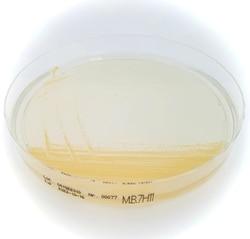
Liofilchem&trade;&nbsp;Middlebrook 7H11 Agar

Prepared Microbiology Media
- (61)
- (348)
- (26)
- (5)
- (2)
- (1)
- (27)
- (25)
- (24)
- (1)
- (7)
- (21)
- (7)
- (1)
- (8)
- (2)
- (2)
- (1)
- (2)
- (16)
- (3)
- (171)
- (1)
- (1)
- (4)
- (2)
- (3)
- (1)
- (14)
- (16)
- (46)
- (12)
- (19)
- (11)
- (11)
- (31)
- (2)
- (492)
- (5)
- (3)
- (2)
- (5)
- (2)
- (2)
- (245)
- (1)
- (7)
- (1)
- (2)
- (54)
- (1)
- (5)
- (1)
- (56)
- (175)
- (5)
- (10)
- (6)
- (1)
- (3)
- (1)
- (1)
- (16)
- (35)
- (9)
- (38)
- (1)
- (24)
- (1)
- (1)
- (1)
- (1)
Filtered Search Results
Liofilchem™ Mueller Hinton II Agar
A medium for antimicrobial susceptibility testing by the disc diffusion technique, according to CLSI and EUCAST
| Manufacturing Origin | Italy |
|---|---|
| Product Type | Prepared Microbiology Plate |
| Sterility | Non-sterile |
Liofilchem™ Haemophilus Test Agar
A medium for susceptibility testing of Haemophilus spp, according to CLSI
Liofilchem™ Chromatic MH
Mueller Hinton agar is a medium for the microbial differentiation simultaneously with susceptibility testing directly from clinical specimens
Liofilchem™ Mueller Hinton II Agar + 2% NaCl
A medium for susceptibility testing of methicillin resistant staphylococcus aureus (MRSA)
Liofilchem™ Schaedler K Agar (Sheep Blood 5%)
A medium for anaerobic bacteria isolation, effective for isolating bacteria
Liofilchem™ Middlebrook 7H11 Agar
A selective agar based medium for the isolation and cultivation of mycobacteria
GVS™ 2mL Ampoules (50 Pack)
Ready-to-use 2mL ampoule is a liquid culture growth media that can save time and money by shortening prep time and minimizing possible contamination. The 2mL ampoules contain enough media to saturate a standard absorbent pad in a petri dish
| Packaging Type | Ampoules |
|---|---|
| Quantity | 2 mL |
| No. per Pack | 50 |
| Certifications/Compliance | Batch-specific quality certificate in each pack |
GVS™ MI Liquid Media Bottled 50mL
Ready-to-use 50mL MI Liquid Media Bottled used to detect presence of coliform bacteria. GVS culture growth media can save time and money by shortening prep time and minimizing possible contamination.
| Manufacturing Origin | United States |
|---|---|
| Detects | presence of coliform bacteria |
| Packaging Type | Bottle |
| Quantity | 50 mL |
| No. per Pack | 1 |
| Certifications/Compliance | Batch-specific quality certificate in each pack |
| Sterility | Sterile |
GVS™ Brilliant Green Bile Bottled Broth with Durham tubes 9mL vials
Brilliant Green Bile Broth is used to detect coliforms in water, milk and other samples. Ready-to-use 9mL ampoules save time and money by shortening prep time and minimizing possible contamination. The 9mL ampoules contain enough media to saturate a standard absorbent pad in a petri dish
Edge Biologicals Streptococcus faecalis Broth
 Small and Specialty Supplier Partner
Small and Specialty Supplier Partner
Small and/or specialty supplier based on Federal laws and SBA requirements.
Learn More

Small and/or specialty supplier based on Federal laws and SBA requirements.
Learn More
Selective medium
Hardy Diagnostics™ GBS Detect™
GBS Detect™ is recommended for the isolation and differentiation by enhanced hemolysis of detection of gamma-hemolytic Group B Streptococcus from GBS enrichment broth procedures.
| Content And Storage | 2°C to 8°C |
|---|---|
| Dimensions (Dia. x H) | 100 x 15 mm |
| Format | Plate |
| Product Type | Agar Plate |
| Diameter (Metric) | 100 mm |
| Color | Red |
| Material | Polystyrene |
| Fill Volume | 17 mL |
| Species | Streptococcus species |
| Sterility | Sterile |
Hardy Diagnostics™ HardyCHROM™ UTI Chromogenic Medium
UTI is a differential culture medium that facilitates the isolation and differentiation of urinary tract pathogens, including gram-negative and gram-positive bacteria
Hardy Diagnostics™ HardyCHROM™ MRSA Chromogenic media
A selective and differential culture medium that facilitates the isolation and identification of methicillin resistant Staphylococcus aureus (MRSA) to aid in the prevention and control of MRSA infections in health care settings.
Hardy Diagnostics™ Mueller Hinton Agar
For antimicrobial susceptibility testing of non-fastidious bacteria by utilizing disk diffusion sensitivity method
Edge Biologicals Heart Infusion Agar Plate
 Small and Specialty Supplier Partner
Small and Specialty Supplier Partner
Small and/or specialty supplier based on Federal laws and SBA requirements.
Learn More

Small and/or specialty supplier based on Federal laws and SBA requirements.
Learn More
Cultivate a wide variety of fastidious and nonfastidious microorganisms

.jpg-250.jpg)






